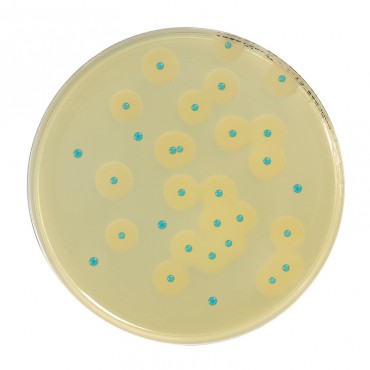

Fraser broth
Fraser broth is used for the selective secondary enrichment of Listeria monocytogenes and other Listeria in food products, according to the standard NF EN ISO 11290-1.
Available in formats of 500g and 5Kg.
For 55 g of dehydrated base media BK133 (Without antibiotics nor ferric ammonium citrate - BS03108)
- Enzymatic digest of animal tissues............................5,0 g
- Enzymatic digest of casein .......................................5,0 g
- Yeast extract .............................................................5,0 g
- Meat extract...............................................................5,0 g
- Sodium chloride.......................................................20,0 g
- Disodium phosphate, anhydrous*..............................9,6 g
- Monopotassium phosphate .....................................1,35 g
- Esculin.......................................................................1,0 g
- Lithium chloride .........................................................3,0 g
For 55 g of dehydrated base media BK115 (including antibiotics - without Ferric ammonium citrate - BS05908 or BS06208)
- Enzymatic digest of animal tissues............................5,0 g
- Enzymatic digest of casein .......................................5,0 g
- Yeast extract .............................................................5,0 g
- Meat extract...............................................................5,0 g
- Sodium chloride.......................................................20,0 g
- Disodium phosphate, anhydrous*..............................9,6 g
- Monopotassium phosphate ....................................1,35 g
- Esculin.......................................................................1,0 g
- Lithium chloride .......................................................3,00 g
- Nalidixic acid ........................................................20,0 mg
- Acriflavin chlorhydrate ............................................25 mg
In compliance with regulatory requirements, a USDA permit (VS 16-3) is mandatory for shipments from Canada to the USA due to the inclusion of peptone, an animal byproduct.
Fraser broth is also available in ready to use format: 50 tubes of 10 ml (BM01308)
The very good recovery of Listeria monocytogenes is assured by the concentration differences in nalidixic acid and acriflavin between Half-Fraser and Fraser, as well as the two enrichment steps themselves. Half-Fraser Broth allows the primary enrichment step, with secondary enrichment being performed in Fraser Broth.
Polypeptone, yeast extract and meat extract furnish the nutrients required for the growth of Listeria.
The high sodium chloride content increases the selectivity of the medium.
Phosphates act as buffers and maintain the pH of the medium.
Esculin is hydrolyzed by Listeria to glucose and esculetin, the latter compound forming a black complex with ferric ions supplied by ferric citrate, added just before use, which also favors the growth of Listeria.
Lithium chloride inhibits the growth of most enterococci which can also hydrolyze esculin.
Nalidixic acid blocks the DNA replication of bacteria sensitive to this antibacterial agent.
The growth of secondary Gram-positive microflora is inhibited by acriflavin.
Related Products